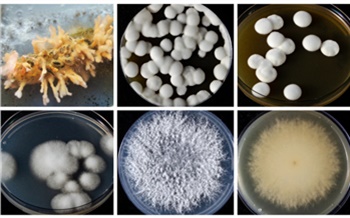
Урожай без химии: красноярские ученые научили грибы и вирусы защищать растения

Сделано в России

Как это сделано? Мы узнаём, встречаясь с авторами известных и необычных проектов, удачно «выстреливших» стартапов и записывая истории их успеха.
Безопасная альтернатива пестицидам

Музей, универмаг и не только


Как красноярские рестораны снова поделили главные награды

От хобби к своему делу

Из отходов — в ценный ресурс


«Чарующий вкус» и другие сладости

Секреты производства и главные хиты

Гаджет, способный упростить жизнь


Вдумчивый анализ и поиск скрытых недочетов

Перспективы экологичного транспорта

Что такое термохимическая обработка и зачем она нужна?


Как работает господдержка реальных дел

На что пошли 100 млн рублей господдержки?

Новое оборудование и рост производства


Получить 19 млн рублей, не потратив ни копейки

Об условиях работы в краевой столице, импортозамещении и патриотизме

Польза нацпроекта для предприятий Красноярского края


Полезные и натуральные десерты по-сибирски

Улучшить продукцию и жизнь работников


Уникальные разработки и новые корпуса завода

Работа регионального проекта по поддержке перспективного бизнеса











